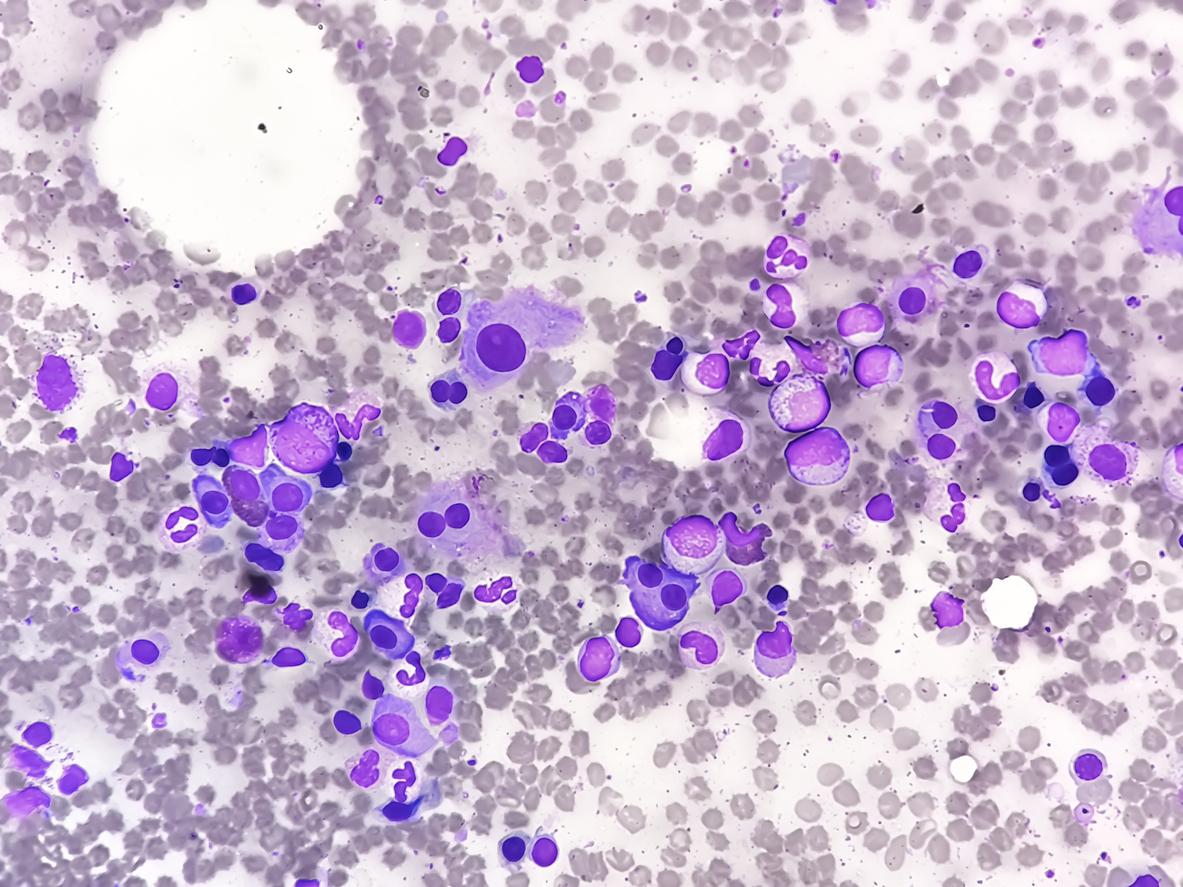

Hématologie
Comparaison de deux scores pour les patients atteints de myélome indolent à haut risque
Une étude de cohorte montre que les critères AQUILA surestiment le risque de progression des patients atteints de myélome indolent, par rapport au modèle 20/20/20.
- Md Saiful Islam Khan/iStock
Un traitement précoce peut être bénéfique pour les patients atteints de myélome multiple indolent à haut risque (HR-SMM), mais des définitions incohérentes du haut risque peuvent conduire à sur- ou sous-traiter certains patients. Le but de cette étude publiée dans Jama Oncology lien est de comparer deux définitions du SMM à haut risque : les critères d’inclusion de l’essai AQUILA et le modèle de stratification du risque 20/20/20.
Deux grandes cohortes de population
L’étude Iceland Screens, Treats, and Prevents Multiple Myeloma (iStopMM) est une vaste étude de dépistage basée sur la population en Islande, menée de 2016 à 2021, tandis que la Danish Lymphoid Cancer Resource (DALY-CARE) est une base nationale de données cliniques au Danemark couvrant la période de 2002 à 2025. Dans la cohorte iStopMM, les individus atteints de SMM ont été identifiés par dépistage. Dans DALY-CARE, les cas de SMM ont été identifiés en contexte clinique.
Définition du SMM à haut risque
Selon les critères AQUILA, le HR-SMM est défini par la présence d’une immunoparésie, d’une protéine monoclonale supérieure à 30 g/L, d’un isotype IgA, d’une plasmocytose médullaire supérieure à 50 %, ou d’un ratio des chaînes légères libres supérieur ou égal à 8.
Selon le modèle 20/20/20, le HR-SMM est défini par la présence d’au moins deux des éléments suivants : pic monoclonal supérieur à 20 g/L, plasmocytose médullaire supérieure à 20 %, ou ratio des chaînes légères libres supérieur à 20.
Les critères AQUILA surestiment le risque de progression
Au total, 193 individus (âge médian [IQR] : 70 [63–72] ans ; 116 [60 %] femmes) issus de la cohorte iStopMM et 1147 individus (âge médian [IQR] : 72 [64–79] ans ; 598 [52 %] femmes) issus de la cohorte DALY-CARE ont été inclus.
Dans la cohorte de dépistage (iStopMM), 65 participants (34 %) présentaient un SMM à haut risque selon les critères AQUILA, et 15 (8 %) selon le modèle 20/20/20.
Dans la cohorte clinique (DALY-CARE), 607 participants (55 %) répondaient aux critères de haut risque selon AQUILA, et 219 (19 %) selon le modèle 20/20/20.
Chez les individus présentant un haut risque défini par AQUILA dans la cohorte clinique, le risque de progression à 2 ans était de 27,0 % (IC 95 % : 23,3 %–30,7 %), avec un taux annuel de progression de14,5 %.
Chez ceux définis à haut risque par le modèle 20/20/20, le risque de progression à 2 ans étaitde 44,1 % (IC 95 % : 37,1 %–51,1 %), avec un taux annuel de progression de 27,3 %.
Conclusion
Cette étude de cohorte montre que les critères de l’essai AQUILA classent environ trois fois plus de patients atteints de SMM comme étant à haut risque par rapport au modèle 20/20/20, avec un risque de progression annuel et à 2 ans nettement plus faible.
Ces résultats suggèrent que le modèle 20/20/20 identifie plus précisément un groupe véritablementà haut risque de SMM, pour lequel un traitement précoce est plus susceptible d’être bénéfique.
































